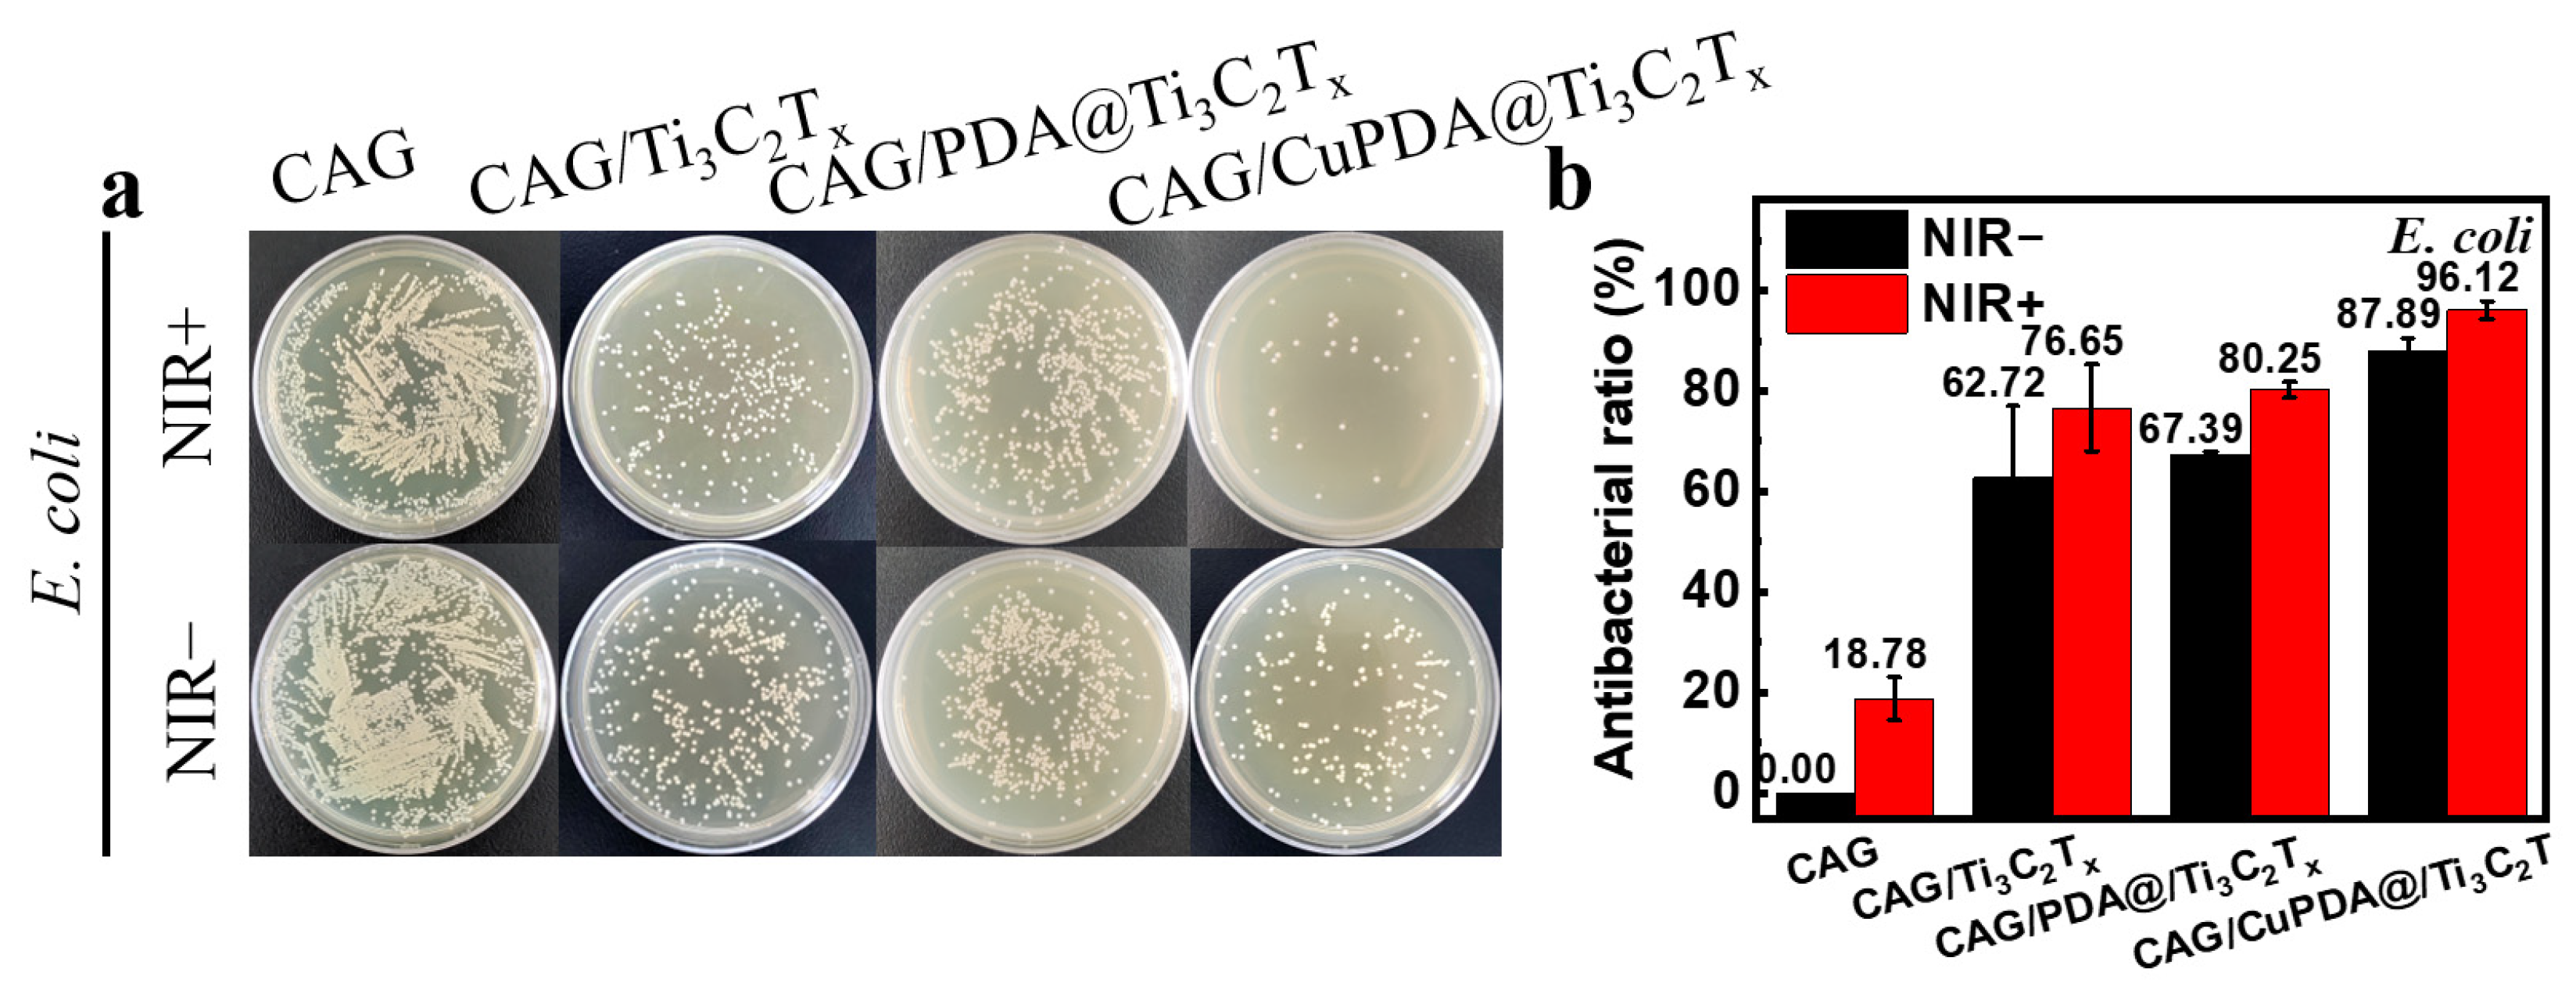
Materials 16 07583 g009

A Synergistic Antibacterial Study of Copper-Doped Polydopamine on Ti3C2Tx Nanosheets with Enhanced Photothermal and Fenton-like Activities
Abstract
:1. Introduction
2. Materials and Methods
2.1. Materials
2.2. Characterization
2.3. Synthesis of Ti3C2Tx Nanomaterials
2.4. Synthesis of CuPDA@Ti3C2Tx
2.5. Preparation of CuPDA@Ti3C2Tx Alginate Hydrogel
2.6. Photothermal Property Calculation
2.7. Antibacterial Measurement
3. Results
3.1. Synthesis and Characterization of Nanocomposites
3.2. Photothermal Properties
3.3. Antibacterial Performance and Mechanism
4. Discussion
5. Conclusions
Author Contributions
Funding
Institutional Review Board Statement
Informed Consent Statement
Data Availability Statement
Conflicts of Interest
References
- Wood, S.J.; Kuzel, T.M.; Shafikhani, S.H. Pseudomonas aeruginosa: Infections, Animal Modeling, and Therapeutics. Cells 2023, 12, 199. [Google Scholar] [CrossRef]
- Mansoorianfar, M.; Shahin, K.; Hojjati-Najafabadi, A.; Pei, R. Mxene-Laden Bacteriophage: A New Antibacterial Candidate to Control Bacterial Contamination in Water. Chemosphere 2022, 290, 133383. [Google Scholar] [CrossRef]
- Brown, D. Antibiotic Resistance Breakers: Can Repurposed Drugs Fill the Antibiotic Discovery Void? Nat. Rev. Drug Discov. 2015, 14, 821–832. [Google Scholar] [CrossRef]
- Kyriakidis, I.; Vasileiou, E.; Pana, Z.D.; Tragiannidis, A. Acinetobacter baumannii Antibiotic Resistance Mechanisms. Pathogens 2021, 10, 373. [Google Scholar] [CrossRef]
- Rojas-Andrade, M.D.; Chata, G.; Rouholiman, D.; Liu, J.L.; Saltikov, C.; Chen, S.W. Antibacterial Mechanisms of Graphene-Based Composite Nanomaterials. Nanoscale 2017, 9, 994–1006. [Google Scholar] [CrossRef]
- Sethulekshmi, A.S.; Saritha, A.; Joseph, K.; Aprem, A.S.; Sisupal, S.B. MoS2 Based Nanomaterials: Advanced Antibacterial Agents for Future. J. Control. Release 2022, 348, 158–185. [Google Scholar] [CrossRef]
- Abbas, M.; Ovais, M.; Atiq, A.; Ansari, T.M.; Xing, R.; Spruijt, E.; Yan, X. Tailoring Supramolecular Short Peptide Nanomaterials for Antibacterial Applications. Coord. Chem. Rev. 2022, 460, 214481. [Google Scholar] [CrossRef]
- Packialakshmi, J.S.; Kang, J.; Jayakumar, A.; Park, S.; Chang, Y.; Kim, J.T. Insights into the Antibacterial and Antiviral Mechanisms of Metal Oxide Nanoparticles Used in Food Packaging. Food Packag. Shelf Life 2023, 40, 101213. [Google Scholar] [CrossRef]
- Franco, D.; Calabrese, G.; Guglielmino, S.P.P.; Conoci, S. Metal-Based Nanoparticles: Antibacterial Mechanisms and Biomedical Application. Microorganisms 2022, 10, 1778. [Google Scholar] [CrossRef]
- Perdikaki, A.; Galeou, A.; Pilatos, G.; Karatasios, I.; Kanellopoulos, N.K.; Prombona, A.; Karanikolos, G.N. Ag and Cu Monometallic and Ag/Cu Bimetallic Nanoparticle-Graphene Composites with Enhanced Antibacterial Performance. ACS Appl. Mater. Interfaces 2016, 8, 27498–27510. [Google Scholar] [CrossRef]
- Cruces, E.; Arancibia-Miranda, N.; Manquián-Cerda, K.; Perreault, F.; Bolan, N.; Azócar, M.I.; Cubillos, V.; Montory, J.; Rubio, M.A.; Sarkar, B. Copper/Silver Bimetallic Nanoparticles Supported on Aluminosilicate Geomaterials as Antibacterial Agents. ACS Appl. Nano Mater. 2022, 5, 1472–1483. [Google Scholar] [CrossRef]
- Gonçalves, R.A.; Ku, J.W.K.; Zhang, H.; Salim, T.; Oo, G.; Zinn, A.A.; Boothroyd, C.; Tang, R.M.Y.; Gan, C.L.; Gan, Y.-H.; et al. Copper-Nanoparticle-Coated Fabrics for Rapid and Sustained Antibacterial Activity Applications. ACS Appl. Nano Mater. 2022, 5, 12876–12886. [Google Scholar] [CrossRef]
- Moskvitina, E.; Kuznetsov, V.; Moseenkov, S.; Serkova, A.; Zavorin, A. Antibacterial Effect of Carbon Nanomaterials: Nanotubes, Carbon Nanofibers, Nanodiamonds, and Onion-Like Carbon. Materials 2023, 16, 957. [Google Scholar] [CrossRef]
- Plachá, D.; Muñoz-Bonilla, A.; Škrlová, K.; Echeverria, C.; Chiloeches, A.; Petr, M.; Lafdi, K.; Fernández-García, M. Antibacterial Character of Cationic Polymers Attached to Carbon-Based Nanomaterials. Nanomaterials 2020, 10, 1218. [Google Scholar] [CrossRef] [PubMed]
- Manivasagan, P.; Kim, J.; Jang, E.-S. Recent Progress in Multifunctional Conjugated Polymer Nanomaterial-Based Synergistic Combination Phototherapy for Microbial Infection Theranostics. Coord. Chem. Rev. 2022, 470, 214701. [Google Scholar] [CrossRef]
- Wang, B.; Feng, G.; Seifrid, M.; Wang, M.; Liu, B.; Bazan, G.C. Antibacterial Narrow-Band-Gap Conjugated Oligoelectrolytes with High Photothermal Conversion Efficiency. Angew. Chem.-Int. Edit. 2017, 56, 16063–16066. [Google Scholar] [CrossRef] [PubMed]
- Jeong, C.J.; Sharker, S.M.; In, I.; Park, S.Y. Iron Oxide@Pedot-Based Recyclable Photothermal Nanoparticles with Poly(Vinylpyrrolidone) Sulfobetairies for Rapid and Effective Antibacterial Activity. ACS Appl. Mater. Interfaces 2015, 7, 9469–9478. [Google Scholar] [CrossRef]
- Bi, X.; Bai, Q.; Liang, M.; Yang, D.; Li, S.; Wang, L.; Liu, J.; Yu, W.W.; Sui, N.; Zhu, Z. Silver Peroxide Nanoparticles for Combined Antibacterial Sonodynamic and Photothermal Therapy. Small 2022, 18, 2104160. [Google Scholar] [CrossRef] [PubMed]
- Mutalik, C.; Okoro, G.; Krisnawati, D.I.; Jazidie, A.; Rahmawati, E.Q.; Rahayu, D.; Hsu, W.-T.; Kuo, T.-R. Copper Sulfide with Morphology-Dependent Photodynamic and Photothermal Antibacterial Activities. J. Colloid Interface Sci. 2022, 607, 1825–1835. [Google Scholar] [CrossRef]
- Younis, M.R.; An, R.B.; Yin, Y.C.; Wang, S.J.; Ye, D.J.; Xia, X.H. Plasmonic Nanohybrid with High Photothermal Conversion Efficiency for Simultaneously Effective Antibacterial/Anticancer Photothermal Therapy. ACS Appl. Bio Mater. 2019, 2, 3942–3953. [Google Scholar] [CrossRef]
- Mo, S.; Song, Y.; Lin, M.; Wang, J.; Zhang, Z.; Sun, J.; Guo, D.; Liu, L. Near-Infrared Responsive Sulfur Vacancy-Rich Cus Nanosheets for Efficient Antibacterial Activity Via Synergistic Photothermal and Photodynamic Pathways. J. Colloid Interface Sci. 2022, 608, 2896–2906. [Google Scholar] [CrossRef] [PubMed]
- Li, X.L.; Huang, Z.D.; Shuck, C.E.; Liang, G.J.; Gogotsi, Y.; Zhi, C.Y. Mxene Chemistry, Electrochemistry and Energy Storage Applications. Nat. Rev. Chem. 2022, 6, 389–404. [Google Scholar] [CrossRef] [PubMed]
- Shekhirev, M.; Shuck, C.E.; Sarycheva, A.; Gogotsi, Y. Characterization of Mxenes at Every Step, from Their Precursors to Single Flakes and Assembled Films. Prog. Mater Sci. 2021, 120, 100757. [Google Scholar] [CrossRef]
- Seidi, F.; Arabi Shamsabadi, A.; Dadashi Firouzjaei, M.; Elliott, M.; Saeb, M.R.; Huang, Y.; Li, C.; Xiao, H.; Anasori, B. Mxenes Antibacterial Properties and Applications: A Review and Perspective. Small 2023, 19, 2206716. [Google Scholar] [CrossRef] [PubMed]
- Cheng, X.J.; Qin, X.J.; Su, Z.L.; Gou, X.; Yang, Z.M.; Wang, H.S. Research on the Antibacterial Properties of Mxene-Based 2D-2D Composite Materials Membrane. Nanomaterials 2023, 13, 2121. [Google Scholar] [CrossRef] [PubMed]
- He, Q.; Hu, H.; Han, J.; Zhao, Z. Double Transition-Metal Tivctx Mxene with Dual-Functional Antibacterial Capability. Mater. Lett. 2022, 308, 131100. [Google Scholar] [CrossRef]
- Rasool, K.; Helal, M.; Ali, A.; Ren, C.E.; Gogotsi, Y.; Mahmoud, K.A. Antibacterial Activity of Ti3C2Tx Mxene. ACS Nano 2016, 10, 3674–3684. [Google Scholar] [CrossRef]
- Sana, S.S.; Santhamoorthy, M.; Haldar, R.; Raorane, C.J.; Iravani, S.; Varma, R.S.; Kim, S.-C. Recent Advances on Mxene-Based Hydrogels for Antibacterial and Drug Delivery Applications. Process Biochem. 2023, 132, 200–220. [Google Scholar] [CrossRef]
- Kumar, R.; Agarwal, S.; Pal, S.; Verma, A.; Prajapati, Y.K. Refractive Index Sensing Using Mxene Mediated Surface Plasmon Resonance Sensor in Visible to near Infrared Regime. Measurement 2024, 224, 113682. [Google Scholar] [CrossRef]
- Zhang, D.; Huang, L.; Sun, D.-W.; Pu, H.; Wei, Q. Bio-Interface Engineering of Mxene Nanosheets with Immobilized Lysozyme for Light-Enhanced Enzymatic Inactivation of Methicillin-Resistant Staphylococcus Aureus. Chem. Eng. J. 2023, 452, 139078. [Google Scholar] [CrossRef]
- Li, M.; Zhang, Y.; Lian, L.; Liu, K.; Lu, M.; Chen, Y.; Zhang, L.; Zhang, X.; Wan, P. Flexible Accelerated-Wound-Healing Antibacterial Mxene-Based Epidermic Sensor for Intelligent Wearable Human-Machine Interaction. Adv. Funct. Mater. 2022, 32, 2208141. [Google Scholar] [CrossRef]
- Li, S.; Gu, B.; Li, X.; Tang, S.; Zheng, L.; Ruiz-Hitzky, E.; Sun, Z.; Xu, C.; Wang, X. Mxene-Enhanced Chitin Composite Sponges with Antibacterial and Hemostatic Activity for Wound Healing. Adv. Healthc. Mater. 2022, 11, 2102367. [Google Scholar] [CrossRef]
- Chidre, P.; Chavan, A.; Hulikunte Mallikarjunaiah, N.; Chandrakanth Revanasiddappa, K. Nanomaterials: Potential Broad Spectrum Antimicrobial Agents. Nat. Prod. Commun. 2023, 18, 1934578 × 221106904. [Google Scholar]
- Azmy, A.; Zhao, X.; Angeli, G.K.; Welton, C.; Raval, P.; Wojtas, L.; Zibouche, N.; Manjunatha Reddy, G.N.; Trikalitis, P.N.; Cai, J.; et al. One-Year Water-Stable and Porous Bi(Iii) Halide Semiconductor with Broad-Spectrum Antibacterial Performance. ACS Appl. Mater. Interfaces 2023, 15, 42717–42729. [Google Scholar] [CrossRef] [PubMed]
- Cuadrado, C.F.; Díaz-Barrios, A.; Campaña, K.O.; Romani, E.C.; Quiroz, F.; Nardecchia, S.; Debut, A.; Vizuete, K.; Niebieskikwiat, D.; Ávila, C.E.; et al. Broad-Spectrum Antimicrobial Znmintpc Encapsulated in Magnetic-Nanocomposites with Graphene Oxide/Mwcnts Based on Bimodal Action of Photodynamic and Photothermal Effects. Pharmaceutics 2022, 14, 705. [Google Scholar] [CrossRef]
- Ma, S.; Luo, X.; Ran, G.; Zhou, Z.; Xie, J.; Li, Y.; Li, X.; Yan, J.; Cai, W.; Wang, L. Copper Stabilized Bimetallic Alloy Cu–Bi by Convenient Strategy Fabrication: A Novel Fenton-Like and Photothermal Synergistic Antibacterial Platform. J. Clean. Prod. 2022, 336, 130431. [Google Scholar] [CrossRef]
- Kumar, S.; Aftab, S.; Singh, T.; Kumar, M.; Kumar, S.; Seo, Y. Charge Storage Improvement in Uniformly Grown TiO2 on Ti3C2Tx Mxene Surface. J. Alloys Compd. 2023, 968, 172181. [Google Scholar] [CrossRef]
- Zheng, Y.; Yan, Y.; Lin, L.; He, Q.; Hu, H.; Luo, R.; Xian, D.; Wu, J.; Shi, Y.; Zeng, F.; et al. Titanium Carbide Mxene-Based Hybrid Hydrogel for Chemo-Photothermal Combinational Treatment of Localized Bacterial Infection. Acta Biomater. 2022, 142, 113–123. [Google Scholar] [CrossRef]
- Shuck, C.E.; Sarycheva, A.; Anayee, M.; Levitt, A.; Zhu, Y.Z.; Uzun, S.; Balitskiy, V.; Zahorodna, V.; Gogotsi, O.; Gogotsi, Y. Scalable Synthesis of Ti3C2Tx Mxene. Adv. Eng. Mater. 2020, 22, 1901241. [Google Scholar] [CrossRef]
- Murali, G.; Reddy Modigunta, J.K.; Park, Y.H.; Lee, J.-H.; Rawal, J.; Lee, S.-Y.; In, I.; Park, S.-J. A Review on Mxene Synthesis, Stability, and Photocatalytic Applications. ACS Nano 2022, 16, 13370–13429. [Google Scholar] [CrossRef]
- Lu, F.; Shi, D.; Tan, P.; Han, Y. A Novel Infrared Electrochromic Device Based on Ti3C2Tx Mxene. Chem. Eng. J. 2022, 450, 138324. [Google Scholar] [CrossRef]
- Gkogkos, G.; Panariello, L.; Grammenou, E.; Cornwell, M.A.; Afrashtehpour, A.; MacRobert, A.J.; Parkin, I.P.; Gavriilidis, A. Synthesis of PEG-PPG-PEG Templated Polydopamine Nanoparticles under Intensified Conditions: Kinetics Investigation, Continuous Process Design and Demonstration for Photothermal Application. Chem. Eng. J. 2023, 467, 143350. [Google Scholar] [CrossRef]
- Behzadinasab, S.; Williams, M.D.; Aktuglu, M.; Falkinham, J.O., III; Ducker, W.A. Porous Antimicrobial Coatings for Killing Microbes within Minutes. ACS Appl. Mater. Interfaces 2023, 15, 15120–15128. [Google Scholar] [CrossRef]
- Vasil’kov, A.; Batsalova, T.; Dzhambazov, B.; Naumkin, A. XPS Study of Silver and Copper Nanoparticles Demonstrated Selective Anticancer, Proapoptotic, and Antibacterial Properties. Surf. Interface Anal. 2022, 54, 189–202. [Google Scholar] [CrossRef]
- Lin, H.; Wang, X.G.; Yu, L.D.; Chen, Y.; Shi, J.L. Two-Dimensional Ultrathin Mxene Ceramic Nanosheets for Photothermal Conversion. Nano Lett. 2017, 17, 384–391. [Google Scholar] [CrossRef]
- Liao, T.; Chen, Z.; Kuang, Y.; Ren, Z.; Yu, W.; Rao, W.; Li, L.; Liu, Y.; Xu, Z.; Jiang, B.; et al. Small-Size Ti3C2Tx Mxene Nanosheets Coated with Metal-Polyphenol Nanodots for Enhanced Cancer Photothermal Therapy and Anti-Inflammation. Acta Biomater. 2023, 159, 312–323. [Google Scholar] [CrossRef] [PubMed]
- Liu, Y.; He, X.; Feng, J.; Wang, D.; Obeng, E.; Yu, C.; Song, Y.; Shen, J.; Li, Z. Engineering a New Member of Mxenes M5C4 Phases Nanoplatforms as Synergistically Photothermal and Chemodynamic Therapeutics for Methicillin-Resistant Staphylococcus Aureus. Chem. Eng. J. 2023, 466, 143004. [Google Scholar] [CrossRef]
- Leem, J.; Vallez, L.; Gill, T.M.; Zheng, X. Machine Learning Assisted Analysis of Electrochemical H2O2 Production. ACS Appl. Energy Mater. 2023, 6, 3953–3959. [Google Scholar] [CrossRef]
- Liu, J.; Wang, X.; Ma, F.; Yang, X.; Liu, Y.; Zhang, X.; Guo, S.; Wang, Z.; Yang, S.; Zhao, R. Atomic Copper(I)-Carbon Nitride as a Peroxidase-Mimic Catalyst for High Selective Detection of Perfluorooctane Sulfonate. Chem. Eng. J. 2022, 435, 134966. [Google Scholar] [CrossRef]
- Liu, H.; Qu, X.; Tan, H.Q.; Song, J.L.; Lei, M.; Kim, E.; Payne, G.F.; Liu, C.S. Role of Polydopamine’s Redox-Activity on Its Pro-Oxidant, Radical-Scavenging, and Antimicrobial Activities. Acta Biomater. 2019, 88, 181–196. [Google Scholar] [CrossRef]
- Roy, S.; Hasan, I.; Guo, B. Recent Advances in Nanoparticle-Mediated Antibacterial Applications. Coord. Chem. Rev. 2023, 482, 215075. [Google Scholar] [CrossRef]
- Hsu, Y.-J.; Nain, A.; Lin, Y.-F.; Tseng, Y.-T.; Li, Y.-J.; Sangili, A.; Srivastava, P.; Yu, H.-L.; Huang, Y.-F.; Huang, C.-C.; et al. Self-Redox Reaction Driven in Situ Formation of Cu2O/Ti3C2Tx Nanosheets Boost the Photocatalytic Eradication of Multi-Drug Resistant Bacteria from Infected Wound. J. Nanobiotech. 2022, 20, 235. [Google Scholar] [CrossRef] [PubMed]
- Borjihan, Q.; Meng, S.; Bai, H.; Chen, T.; Hu, X.; Xiao, D.; Shi, L.; Dong, A. Active Iodine Regulated in Cow Dung Biochar-Based Hydrogel Combined with PDT/PTT for MRSA Infected Wound Therapy. Mater. Design 2023, 231, 112051. [Google Scholar] [CrossRef]
- Awad, M.; Thomas, N.; Barnes, T.J.; Prestidge, C.A. Nanomaterials Enabling Clinical Translation of Antimicrobial Photodynamic Therapy. J. Control. Release 2022, 346, 300–316. [Google Scholar] [CrossRef] [PubMed]

Disclaimer/Publisher’s Note: The statements, opinions and data contained in all publications are solely those of the individual author(s) and contributor(s) and not of MDPI and/or the editor(s). MDPI and/or the editor(s) disclaim responsibility for any injury to people or property resulting from any ideas, methods, instructions or products referred to in the content. |
© 2023 by the authors. Licensee MDPI, Basel, Switzerland. This article is an open access article distributed under the terms and conditions of the Creative Commons Attribution (CC BY) license (https://creativecommons.org/licenses/by/4.0/).
Share and Cite
Fang, Z.; Zhou, Q.; Zhang, W.; Wang, J.; Liu, Y.; Yu, M.; Qiu, Y.; Ma, Z.; Liu, S. A Synergistic Antibacterial Study of Copper-Doped Polydopamine on Ti3C2Tx Nanosheets with Enhanced Photothermal and Fenton-like Activities. Materials 2023, 16, 7583. https://doi.org/10.3390/ma16247583
Fang Z, Zhou Q, Zhang W, Wang J, Liu Y, Yu M, Qiu Y, Ma Z, Liu S. A Synergistic Antibacterial Study of Copper-Doped Polydopamine on Ti3C2Tx Nanosheets with Enhanced Photothermal and Fenton-like Activities. Materials. 2023; 16(24):7583. https://doi.org/10.3390/ma16247583
Chicago/Turabian StyleFang, Zhuluni, Qingyang Zhou, Wenbo Zhang, Junyi Wang, Yihan Liu, Miao Yu, Yunfeng Qiu, Zhuo Ma, and Shaoqin Liu. 2023. "A Synergistic Antibacterial Study of Copper-Doped Polydopamine on Ti3C2Tx Nanosheets with Enhanced Photothermal and Fenton-like Activities" Materials 16, no. 24: 7583. https://doi.org/10.3390/ma16247583
APA StyleFang, Z., Zhou, Q., Zhang, W., Wang, J., Liu, Y., Yu, M., Qiu, Y., Ma, Z., & Liu, S. (2023). A Synergistic Antibacterial Study of Copper-Doped Polydopamine on Ti3C2Tx Nanosheets with Enhanced Photothermal and Fenton-like Activities. Materials, 16(24), 7583. https://doi.org/10.3390/ma16247583








